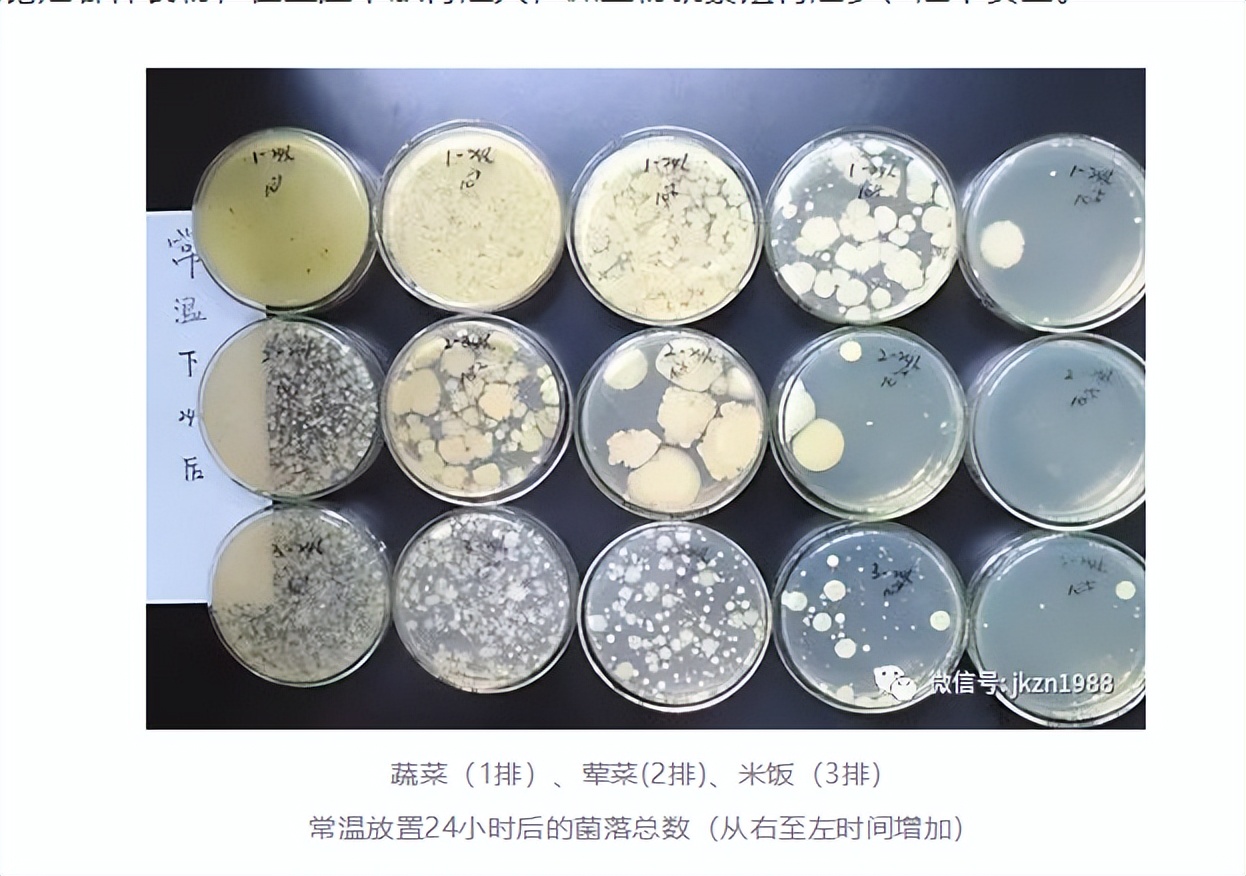

问鼎娱乐下载入口 一碗隔夜饭,10日ICU?隔夜米饭能不能吃?这4种食物尽量别隔夜
一碗隔夜饭,10日ICU?
小李,28岁,结束了一天的忙碌,本打算叫份外卖,可是一想到要节省开支,便决定将冰箱中剩余的隔夜蛋炒饭稍微热一下,便自行享用。
小李起初只是感到腹部不适,未曾想疼痛逐渐加剧,以至于出现了恶心和腹泻,频率之高让他难以忍受。在经历了多次周折后,小李终于决定前往一家知名医院寻求治疗。
消化内科接收了一名患有急性肝衰竭的患者,名叫小李。他的肝功能和凝血功能均出现严重异常,并且还伴有肾衰竭的症状,初步判断可能是食物中毒所致。在接到检验科的报告后,首诊医生迅速作出决定,将小李转至重症监护室接受进一步治疗。
小李的病情恶化,中毒症状显著,身处险境,ICU的医护人员迅速采取“人工肝”技术对患者展开紧急救治。血液检测结果显示,小李感染了大肠埃希菌,经过抗生素治疗后,病情才得以逐步好转,他在ICU接受治疗共计10天。

大肠埃希菌,这种存在于人和动物肠道中的正常菌群,同时也是一种能够致病的微生物。当人体免疫力减弱时,它可能引发以尿路感染为主的多种感染疾病,诸如腹泻、菌血症、脓毒血症等,其危害性不容忽视。那么,隔夜米饭是否还能安全食用呢?
一、隔夜米饭能不能吃?
隔夜米饭存在三个主要健康风险,首先是营养价值的减少,其次是食物中可能含有的化学成分,最后是微生物的大量滋生,尤其是细菌的再次污染。常见的能引起疾病的微生物有沙门氏菌、弯曲杆菌、大肠杆菌、李斯特菌等,一旦发生食物中毒,患者可能会出现发热、恶心、肚子痛、腹泻等症状。

隔夜食物能否吃,关键看储存条件和储存时间。
在室温中放置一晚的剩菜、剩饭、汤、凉菜以及卤味不宜食用,因为它们可能含有过多的细菌,从而引发腹泻。世卫组织指出问鼎娱乐app苹果下载,熟食在室温中存放不应超过两小时。这是因为食物一旦降至60℃,细菌便开始繁殖,而温度在30℃至40℃之间时,细菌的繁殖速度会变得非常快。鉴于此,建议在米饭还热的时候,就放入冰箱保存。
众多人在米饭冷却后才会将其存入冰箱,担心因此损害冰箱。然而,不论何种食材,若在常温下存放时间过长,其上生长的微生物数量便会显著增加。
即便是在低温的冰箱环境中,细菌的生长也仅仅是被遏制,并未完全停滞,因此,尽管可能会增加一些电费,但从健康的角度考虑,也应当尽早将食物放入冰箱保存。
关于隔夜食物中的亚硝酸盐水平,通常来说问鼎app官网下载安装,只要储存得当,很难导致急性中毒,因为与中毒所需的剂量相比,还相去甚远。然而,隔夜饭菜不仅口感不佳,而且大部分营养素已经丧失,因此,我们仍建议大家尽量减少食用。
图源:健康指南
二、米饭二次加热会致癌?
关于米饭二次加热可能致癌的观点,部分人认为经过加热的过程并不能彻底去除米饭中细菌所制造的毒素,因而存在引发癌症的潜在风险。
实际上,在储存过程中,米饭有可能产生细菌,然而,经过再次加热的米饭与癌症之间并没有直接的因果关系。
除了有关米饭再次加热可能致癌的说法之外,还有流言指出,鸡肉在经过二次加热后,其中的蛋白质在储存过程中可能会生成蛋白质分解产物,这不仅可能损害肝肾健康,还存在致癌的可能性。
实际上,蛋白质分解的产物主要是氨基酸与多肽,这两种物质并不构成对肝肾的潜在危害,然而这种观点并不可靠。

三、隔夜食物的正确存放指南
除了之前所述的需迅速放入冰箱之外,以下几项措施同样有助于降低风险。
首先应减少对食物的翻动,尤其是避免使用筷子等餐具,以防交叉感染的发生;在储存过程中,应使用保鲜盒或保鲜膜,确保其密封性良好。
其次,应将食物分开存放,确保熟食与生食严格隔离,防止相互传染。对于分量较大的食物,建议分切成若干份问鼎娱乐官网下载,这样做有助于加速食物的降温过程。
另外,剩菜冷藏条件存放(2~8℃),并尽快食用。
食用前,剩菜剩饭必须完全加热,确保细菌被彻底消灭。“热透”的标准是,将菜肴整体加热至100℃,并维持蒸锅中的水持续沸腾超过3分钟;若为肉类,则需加热超过10分钟,方可安全食用。

四、4种食物不建议隔夜吃
即便将隔夜茶妥善封存于保鲜膜或保鲜盒中,并迅速冷藏,这样的茶依然可以安全食用,然而对于以下几种,我仍推荐大家优先选择新鲜泡制的。
·汤类
饮用前应先盛出所需份额,未喝完的汤汁宜置于陶瓷瓦罐中保存在冷藏室内。若长时间存于不锈钢或铝制容器中,则可能引发不良的化学反应。
·散装卤味
卤制品本身潜藏食品安全风险,即便存放在冷藏环境中,剩余部分也难以有效遏制细菌的繁殖,尤其是嗜冷菌这类微生物。

·银耳
银耳和木耳在泡发状态下,极易受到椰毒假单胞菌的污染。这种细菌在常温条件下能生成一种耐高温的米酵菌酸毒素。通常情况下,只需浸泡1至2小时即可进行加工。然而,由于不适合长时间浸泡存储,因此不宜长时间浸泡。
·溏心蛋
若非经过杀菌处理的鸡蛋,其半熟状态下的杀菌效果往往不尽人意,且鸡蛋富含多种营养,这使其更易成为细菌滋生的温床,因此,出于卫生考虑,建议不宜留至隔日食用。
偶尔食用一两顿剩菜剩饭,身体可能不会有任何不适。然而,许多可能导致疾病的细菌是肉眼难以察觉的。因此,为了确保安全,最好按照食用的量来烹饪,这样既不会造成浪费,又能有效预防食品安全风险。
参考资料:
 鲁ICP备18019460号-4
鲁ICP备18019460号-4
我要评论